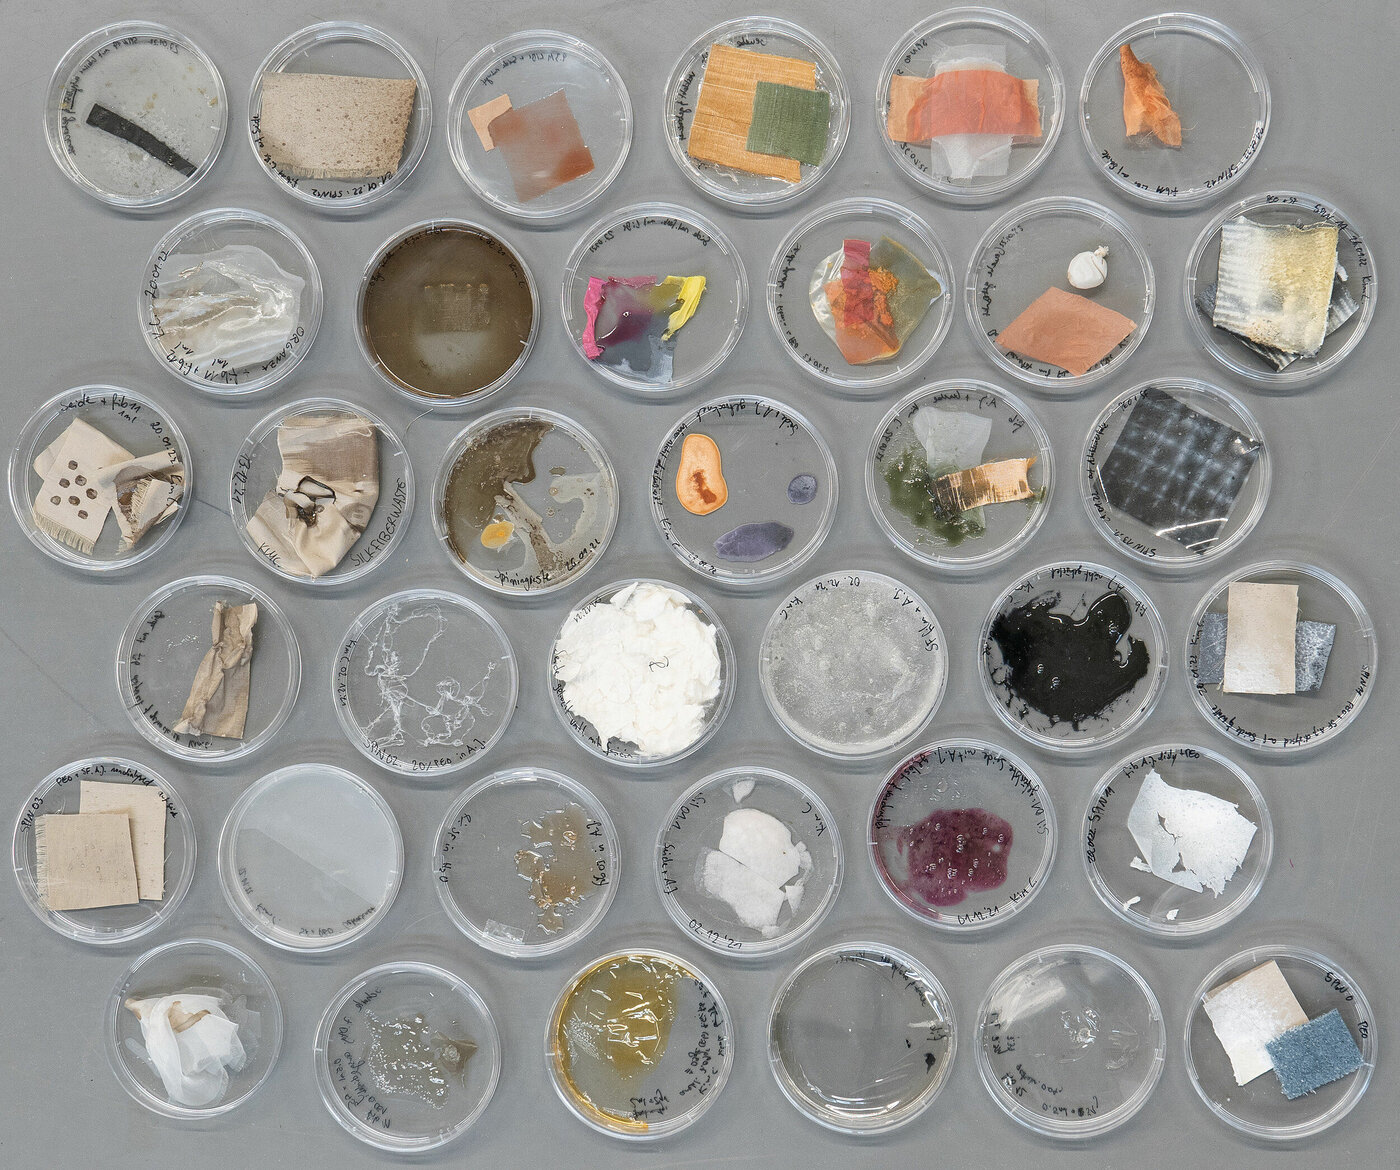

silcularity vitalizing silk layers silcularity describes a process to embed bombyx mori, mulberry silk, as a circular material. For this purpose, a natural solvent was developed which dissolves silk fibroins out of cocoons, mixed fabrics and production left overs. In addition it is shown that the original colour can be retained and the liquid fibroin …

material
technology
sustainability
design
Projects of Prof. Mareike Gast at Burg Giebichenstein University of Art and Design